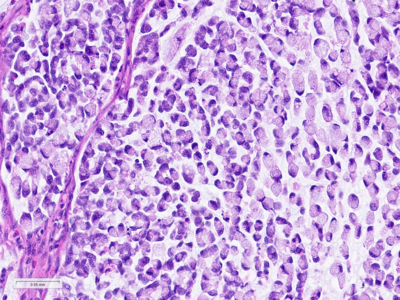
ENGIP

-
Die Universität
- Herzlich willkommen
- Das sind wir
- Medien & PR
-
Studium
- Allgemein
- Studienangebot
- Campusleben
-
Forschung
- Profil
- Infrastruktur
- Kooperationen
- Services
-
Karriere
- Arbeitgeberin Med Uni Graz
- Potenziale
- Arbeitsumfeld
- Offene Stellen
-
Diagnostik
- Patient*innen
- Zuweiser*innen
- Gesundheitsthemen
- Gesundheitsinfrastruktur
Case of the Month
April 2026
Partial resection of a gastric tumour in a 92-year-old male.
Diagnosis
Mixed-type gastric carcinoma.
Comment
A 92-year-old man diagnosed with gastric cancer underwent a partial gastrectomy. On gross examination, the specimen measured 11×6 cm and a 4.5 cm tumour was identified 2 cm from the distal margin within the antrum.
Histologically, the tumour was confirmed to be an adenocarcinoma invading through the gastric submucosa into the muscularis propria (Panel A), showing multiple architectural patterns. While the majority of the lesion displayed a tubular and papillary arrangement of neoplastic cells (Panel B), there were also mucin pools containing floating tumour cells (Panel C), as well as areas of discohesive signet-ring cells (Panel D), so called for their intracytoplasmic mucin droplet that eccentrically displaces the nucleus. The different architectural patterns were not entirely independent of each other nor were they intermingled, but rather arranged side by side (Panel E).
Immunohistochemical analysis of mismatch repair proteins demonstrated loss of MLH1 (Panel F) and PMS2 expression. MSH2 and MSH6 expression were retained.
While gastric adenocarcinomas may exhibit intratumoral architectural heterogeneity, a lesion that displays a mixture of different histological subtypes and one of them is a signet-ring cell/poorly cohesive carcinoma is classified as a mixed carcinoma, mixed adenocarcinoma or mixed-type carcinoma/adenocarcinoma.
Mixed carcinomas have been shown to share a common clonal origin among their different architectural components and tend to exhibit more aggressive features such as larger size, deeper invasion and higher rates of lymph node metastasis. Although the different types of gastric adenocarcinoma are associated with distinct prognoses - diffuse-type adenocarcinomas being known to have a worse prognosis - in mixed gastric carcinomas, the relative proportion of each component does not appear to have prognostic significance.
Microsatellite instability represents one of the four proposed molecular subtypes of gastric adenocarcinoma and is present in less than a quarter of cases, without clear association with any histological subtype.
For further reading
Zheng HC, Li XH, Hara T, et al. Mixed-type gastric carcinomas exhibit more aggressive features and indicate the histogenesis of carcinomas. Virchows Arch. 2008;452(5):525–534.
Drebin HM, Walch H, Da Silva EM, et al. Genomic Signatures of Gastric Adenocarcinoma By Tumor Location-Modified Lauren Classification: Highlighting the Molecular Heterogeneity of Mixed-Type Tumors. Am J Surg Pathol. 2025;49(9):948-955.
Presented by
Dr. Ana Lucia Alves, Coimbra, Portugal, and Dr Cord Langner, Graz, Austria.